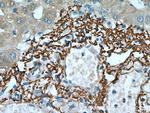
Vitronectin Antibody in Immunohistochemistry (Paraffin) (IHC (P))

Search
Proteintech
Vitronectin Polyclonal Antibody
{{$productOrderCtrl.translations['antibody.pdp.commerceCard.promotion.promotions']}}
{{$productOrderCtrl.translations['antibody.pdp.commerceCard.promotion.viewpromo']}}
{{$productOrderCtrl.translations['antibody.pdp.commerceCard.promotion.promocode']}}: {{promo.promoCode}} {{promo.promoTitle}} {{promo.promoDescription}}. {{$productOrderCtrl.translations['antibody.pdp.commerceCard.promotion.learnmore']}}
产品信息
15833-1-AP
种属反应
已发表种属
宿主/亚型
分类
类型
抗原
偶联物
形式
浓度
规格
纯化类型
保存液
内含物
保存条件
运输条件
产品详细信息
Immunogen sequence: EVGASKPEG IDSRPETLHP GRPQPPAEEE LCSGKPFDAF TDLKNGSLFA FRGQYCYELD EKAVRPGYPK LIRDVWGIEG PIDAAFTRIN CQGKTYLFKG SQYWRFEDGV LDPDYPRNIS DGFDGIPDNV DAALALPAHS YSGRERVYFF KGKQYWEYQF QHQPSQEECE GSSLSAVFEH FAMMQRDSWE DIFELLFWGR TSAGTRQPQF ISRDWHGVPG QVDAAMAGRI YISGMAPRPS LAKKQRFRHR NRKGYRSQRG HSRGRNQNSR RPSRAMWLSL FSSEESNLGA NNYDDYRMDW LVPATCEPIQ SVFFFSGDKY YRVNLRTRRV DTVDPPYPRS IAQYWLGCPA PGHL (126-478 aa encoded by B C005046)
靶标信息
VTN is a member of the pexin family. This protein is found in serum and tissues and promotes cell adhesion and spreading, inhibits the membrane-damaging effect of the terminal cytolytic complement pathway, and binds to several serpin serine protease inhibitors. The protein is a secreted protein and exists in either a single chain form or a clipped, two chain form held together by a disulfide bond.
仅用于科研。不用于诊断过程。未经明确授权不得转售。
生物信息学
蛋白别名: complement S-protein; epibolin; S-protein; serum spreading factor; Serum-spreading factor; somatomedin B; unnamed protein product; V75; Vitronectin; VN
基因别名: Aa1018; AI256434; V75; VN; VNT; VTN
UniProt ID: (Human) P04004, (Mouse) P29788
Entrez Gene ID: (Human) 7448, (Rat) 29169, (Mouse) 22370